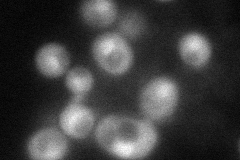
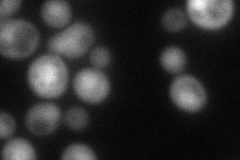
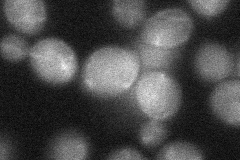
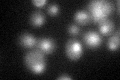

View description
U2-snRNP associated splicing factor with similarity to the mammalian splicing factor SAP49; proposed to function as a U2-snRNP assembly factor along with Hsh155p and binding partner Cus1p; contains two RNA recognition motifs (RRM)
Localization:
Intensity:
Fold change:
Significance:
-
C’ GFP library in SD

nucleus27.14 -
N' NOP1pr-GFP in SD
cytosol,nucleus71.918 -
N' TEF2pr-mCherry in SD
nucleus61.0609 -
N' NATIVEpr-GFP in SD

nucleus33.1405 -
N' TEF2pr-VC and Cyto-VN in SD
cytosol,nucleus31.6526 -
C’ GFP library in SD+DTT
nucleus27.671.01No -
C’ GFP library in SD+H2O2

nucleus22.520.82No -
C’ GFP library in Starvation Media

nucleus30.521.12No -
C’ GFP library on the background of Pup2-DaMP

nucleus -
C’ GFP library on the background of CCT mutant

nucleus27.48621.01258No
